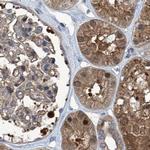
PSMB1 Antibody in Immunohistochemistry (IHC)

Search
Invitrogen
PSMB1 Polyclonal Antibody
{{$productOrderCtrl.translations['antibody.pdp.commerceCard.promotion.promotions']}}
{{$productOrderCtrl.translations['antibody.pdp.commerceCard.promotion.viewpromo']}}
{{$productOrderCtrl.translations['antibody.pdp.commerceCard.promotion.promocode']}}: {{promo.promoCode}} {{promo.promoTitle}} {{promo.promoDescription}}. {{$productOrderCtrl.translations['antibody.pdp.commerceCard.promotion.learnmore']}}
产品信息
PA5-56218
种属反应
宿主/亚型
分类
类型
抗原
偶联物
形式
浓度
规格
纯化类型
保存液
内含物
保存条件
运输条件
RRID
产品详细信息
Immunogen sequence: YQRDSFKAGG SASAMLQPLL DNQVGFKNMQ NVEHVPLSLD RAMRLVKDVF ISAAERDVYT GDALRICIVT KEGIREETVS LRKD
Highest antigen sequence identity to the following orthologs: Mouse - 98%, Rat - 98%.
靶标信息
PSMB1 is a multicatalytic proteinase complex which is characterized by its ability to cleave peptides with Arg, Phe, Tyr, Leu, and Glu adjacent to the leaving group at neutral or slightly basic pH. The proteasome has an ATP-dependent proteolytic activity.
仅用于科研。不用于诊断过程。未经明确授权不得转售。
篇参考文献 (0)
生物信息学
蛋白别名: beta-6; Macropain subunit C5; Multicatalytic endopeptidase complex subunit C5; proteasome (prosome, macropain) subunit, beta type, 1; proteasome beta 1 subunit; Proteasome component C5; Proteasome gamma chain; proteasome subunit beta 1; Proteasome subunit beta type-1; Proteasome subunit beta-6; proteasome subunit beta6; proteasome subunit HC5; testicular secretory protein Li 45
基因别名: HC5; NEDMHAL; PMSB1; PSC5; PSMB1
UniProt ID: (Human) P20618
Entrez Gene ID: (Human) 5689